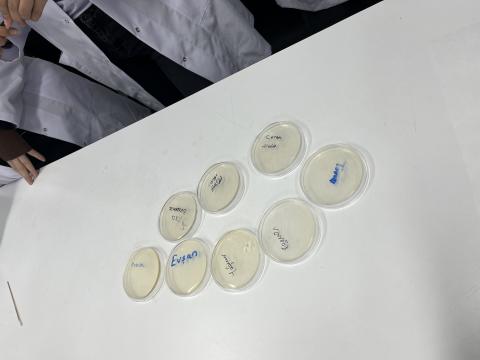
Mikrobiyoloji çalıştayı

Yerel Birlik
İnönü Tıp Öğrencileri Birliği

E-Posta Adresi
dgn44makbule@gmail.com
Bu ay içerisinde gerçekleştirmiş olduğunuz etkinliğin adı nedir?
Mikrobiyoloji Çalıştayı
Bu etkinliği düzenlemek istemenizdeki hedefler ve etkinliğinizin içeriği nelerdir?
Katılımcılarımızın kişisel eşyalarından örnek alıp ekim yapmak ve çıkan sonuçları değerlendirmek. Kültür ekiminin nasıl yapıldığını detaylıca öğrenmek.
Bu etkinliğin hazırlık sürecinde ve sonrasında sizi en çok zorlayan kısmı ne oldu?
Laboratuvar koşullarında yapılan bir etkinlik olduğu için bu ortamda güvenliği sağlamak ve etkinlik boyunca hijyene dikkat etmek oldu başarılı bir şekilde altından kalktık.
Bu etkinliğin sürdürülebilirliği ile ilgili düşünceleriniz nelerdir?
Tıp eğitimi boyunca karşımıza her çıkan mikrobiyoloji dalını daha yakından tanımak için çok iyi bir etkinlik oldu. Uzun zamanda etkisi kalıcı olacaktır.
Bu etkinlikten almış olduğunuz verimi nedenleriyle açıklayabilir misiniz?
Öncelikle ekimin nasıl yapıldığını öğrendik. Hocalarımız bize önderlik ettiği için aklımıza takılan her soruda doğru cevap alabildik. Toplu bir çalışma olduğu için de katılımcılar arası etkileşim arttı
Etkinliğin kazanımları ve başarı göstergeleri nelerdir?
Etkinlik hakkındaki geri dönüşler olumlu yöndeydi. Kazanımlarımız ise bakteri ekiminin nasıl yapıldığını öğrenmek ve Mikrobiyoloji laboratuvarını yakından incelemek oldu.
Eklemek istedikleriniz?
Teşekkürler 🫶🏻
Etkinliğin gerçekleştirilme tarihi
